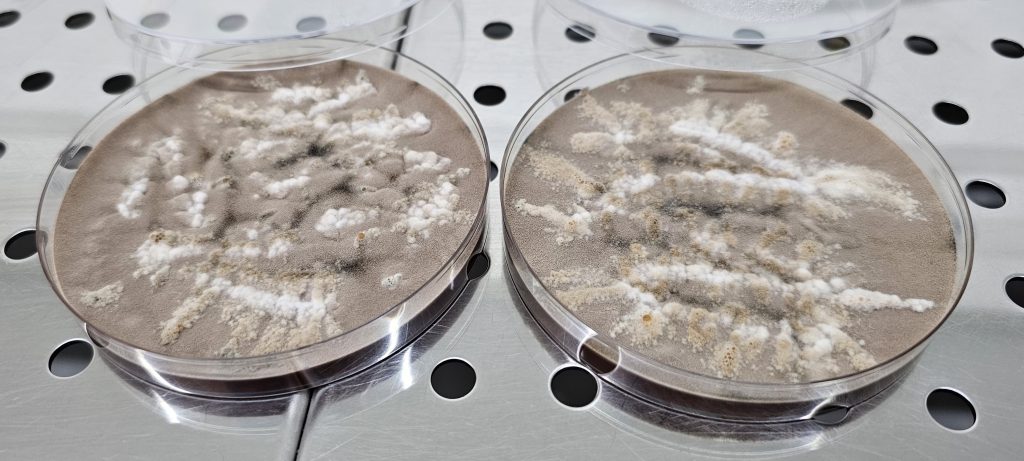

Olombrada et al. 2017
Clinical context
Aspergillosis refers to a group of diseases caused by fungi of the genus Aspergillus, whose spores are widely present in the environment and regularly inhaled by humans.
In most healthy individuals, these spores are naturally eliminated by the immune system without causing illness. However, people with weakened immunity or pre-existing lung conditions are at greater risk of developing infection.
The disease can take different forms, ranging from allergic reactions affecting the airways to chronic lung infections. The most severe type, invasive aspergillosis, primarily affects immunocompromised patients and can spread beyond the lungs to other organs.
Symptoms are often nonspecific, especially in early stages, which can make diagnosis challenging. Medical imaging and specialized laboratory tests are usually required to confirm the infection. Treatment depends on the clinical form and generally involves antifungal medications, particularly azole drugs.
In high-risk patients, careful monitoring and preventive measures are essential to reduce the likelihood of severe complications.
Our products
- AF01 : Aspergillus fumigatus, dried antigens extracted from culture
- AF02 : Aspergillus fumigatus gDNA